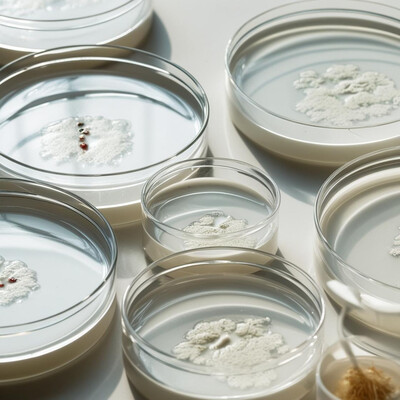

- カテゴリから探す
- コラボメーカーとは
- ご利用ガイド
- 導入事例
- ラボを貸す・受託する


分析機器データ管理サービスです。
分析機器付属のPCから結果ファイルを自動アップロード。
回収されたファイルからメタデータを抽出、メタデータとしてデータベースに登録、及びビジュアル化したデータを表示します。これらにより、検索を容易にし、簡単にデータにアクセス可能にすることができます。研究データをより有効活用するためのFAIR PrinciplesFindable(見つけられる)、Accessible(アクセス可能)、Interoperable(相互運用)、Reusable(再利用できる)を実現します。


高精度電子ピペット(ザルトリウス製)、独自制御『LabCraft』、3Dプリント製カスタムパーツを組合せ、標準装置では困難なピペッティング作業(特殊容器・液体、微量操作、既存装置連携等)をオーダーメイドで自動化します。


市販品では対応できない特殊な実験器具の固定、ロボットアームでのサンプルや容器のハンドリングなどを実現するため、3D CAD設計と3Dプリント技術を駆使し、お客様専用のカスタムパーツ(エンドエフェクタ、治具、ホルダー等)を設計・製作します。
化学・生物学研究室のニーズを熟知:溶媒耐性など、用途に応じた最適な材料選定・設計が可能
アイデア力で「できない」を形に:固定観念にとらわれない発想で最適な治具・パーツを提案
複雑形状も迅速に実現:3D CAD設計と3Dプリントで、切削加工では難しい形状も製作可能
スピード感のある試作:ラピッドプロトタイピングで、設計・評価サイクルを高速化
コスト効率の良い選択肢:1点からのオーダーメイドでも、加工法によりコストを抑えた提案が可能


ピペッティングに留まらず、サンプルの搬送・投入・回収、反応プロセスの自動制御、データ自動取得、物理測定など、研究開発における様々な手作業プロセスを自動化します。ロボットアーム、カスタムハードウェア(3Dプリント等)、センサー、ソフトウェアを最適に統合し、お客様専用の自動化システムをゼロベースか...
多様なプロセスへの対応力: ピペッティング、マテリアルハンドリング、測定、反応制御など、幅広い自動化ニーズに柔軟に対応。
システムインテグレーション技術: 複数機器(ロボット、センサー、既存装置)を連携させた複雑な自動化システム構築力。
カスタムハードウェア開発: 3Dプリント等を活用し、最適なメカニズムや治具をゼロから設計・製作。
柔軟な制御ソフトウェア: 『LabCraft』等を活用し、複雑なプロセスも比較的容易に制御・変更可能。
アイデアによる本質的課題解決: 既存手法にとらわれず、経験豊富なエンジニアが最適な自動化アプローチを提案。


素材や機器などから発生する目には見えない微粒子を撮影して比較評価します。 高清浄度クリーンルームでバックグラウンドの粉塵を除去したうえで、超高感度型微粒子可視化システムにより、微粒子の発塵箇所、発塵のタイミング、粒子が発生する条件、発生した粒子の挙動などを映像化します。


高感度な光膜式モニタリング技術を応用した、供試体から発生する微粒子を全量評価する技術です。供試体を試験チャンバ内に設置し、その供試体から発生した全ての微粒子を、検出部でリアルタイムに映像化し計数します。
・試験方法の要望対応可能
・試験計画の立案可能
厳しい清浄度管理が要求される分野で用いる機械や器具の発塵性を検証することができます。高速サンプリング技術により、応答性の高い測定が可能です。発生量に時間変化がある試験体も、その変化を忠実に計測できます。個数データとともに微粒子を可視化した動画も記録できます。データのエビデンスをリアルタイム映像として取得することもできます。
各種素材、クリーン用品、機器駆動部、電気用品、気密製品、電動工具など


アレルゲンを低減化させることを目的として開発される家電製品、繊維製品、素材、液剤等の効果を試験規格に準じた方法で評価します。 アレルゲンとしては、スギ花粉、ダニアレルゲンの試験が可能です。 試験規格が制定されていない試験品については、抗菌試験や抗ウイルス試験等の試験規格を参考にした方法で評価を...